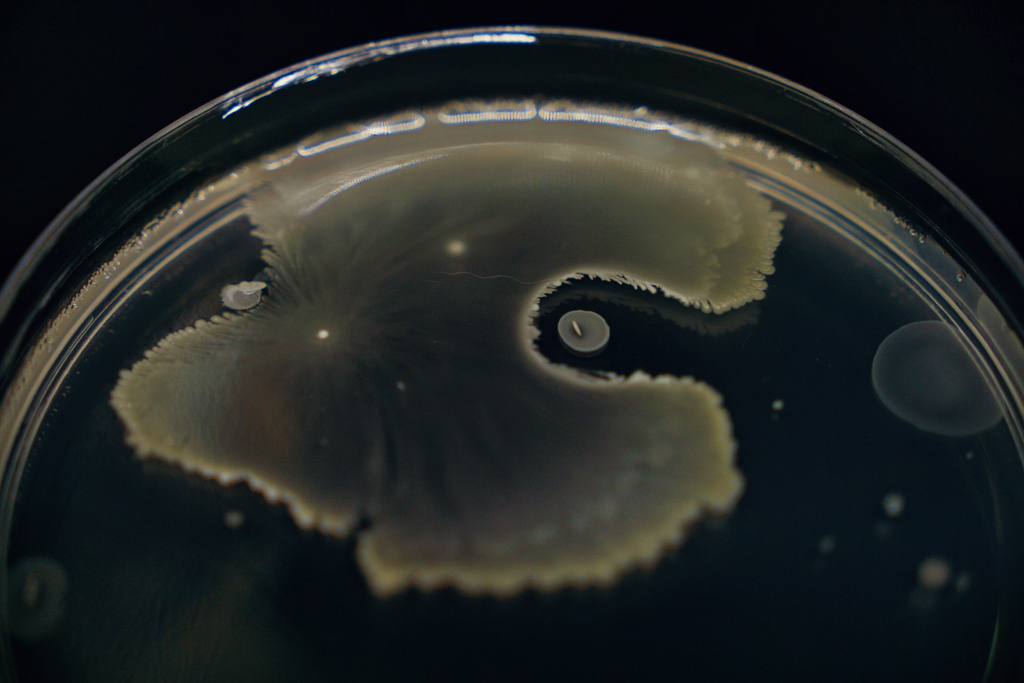

For a detailed overview of Aurigene’s microbiological capabilities, download our flyer.
Microbiology:
the silent guardian of drug efficacy
During the H1N1 influenza pandemic in 2009, several governments around the world invested billions in antiviral stockpiles, particularly focusing on Tamiflu (oseltamivir). The panic was so intense that the global stockpile reached over 65 million treatment courses in the United States alone, reflecting a collective commitment to pandemic preparedness.
However, a report published in Nature[i] later challenged the efficacy claims of Tamiflu. The report suggested that the ability to Tamiflu to prevent severe outcomes and reduce transmission might have been overstated. This sparked widespread debates about the true value of such stockpiles, thereby raising critical questions about the processes that determine drug quality and reliability.

This incident turns our attention to a pivotal truth: the success of any pharmaceutical intervention relies heavily on microbiological rigor. As highlighted in an analysis published in PubMed[ii], the effectiveness of pandemic stockpiles is decided by more than just availability—it demands microbiological excellence .
Microbial contamination, stability failures, or deviations from regulatory standards can render millions of doses useless when they are needed the most. Microbiological testing ensures that drugs remain sterile, potent, and safe under diverse storage conditions, ensuring their availability for deployment in emergencies.
In the pharmaceutical industry, microbiology validates sterility in production, confirms shelf lives through stability studies, and ensures adherence to global safety standards. Without these efforts, the billions invested in pandemic preparedness could fail to deliver life-saving outcomes, leaving populations vulnerable when crises strike.
The broader picture of
pharmaceutical microbiology
The journey from an innovative pharmaceutical concept to a life-saving medicine is fraught with invisible threats—microbial contaminants, endotoxins, and biofilm-forming organisms that can compromise safety and efficacy. Pharmaceutical microbiology ensures that every dose of medication is as pure as it is effective.
If the story of Tamiflu demonstrated the importance of microbiology in global pandemic preparedness, the broader field reveals its indispensable role in every step of pharmaceutical production to uphold the highest standards of safety and trust.
Connect with our scientific experts for your drug discovery, development and manufacturing needs
Pharmaceutical microbiology tests
Pharmaceutical microbiology tests are essential quality control measures that ensure drugs are free from microbial contamination, maintain stability, and comply with global safety standards. These tests validate sterility, confirm shelf life, and safeguard the efficacy of pharmaceutical products.

Bugs as drugs: microbes in therapeutics
Pharmaceutical microbiology is no longer solely about defense. Rather, microbes themselves are being harnessed as therapies, with applications ranging from gut health to cancer treatment. These “bugs as drugs” represent the cutting edge of microbiological innovation, pushing the boundaries of what microbes can achieve in medicine.
CDMO expertise: a trusted partner in microbiological excellence
CDMOs integrate these microbiological services into their offerings, acting as invaluable partners for pharmaceutical companies. They ensure that sterility, contamination control, and stability testing are performed with unmatched precision. Moreover, CDMOs are at the forefront of adopting advanced techniques like rapid microbial testing, offering tailored solutions that meet both regulatory and operational demands.
What Aurigene offers
At Aurigene, our journey in pharmaceutical microbiology is fueled by an unwavering commitment to innovation, precision, and excellence. Our state-of-the-art infrastructure, expert team, and comprehensive service portfolio position us as a trusted partner for pharmaceutical companies seeking microbiological expertise.
Aurigene facilities: where precision meets possibility
The foundation of our microbiology services lies in our advanced facilities:
and fungal infections, providing a robust platform for efficacy studies and pharmacodynamic research.
With these facilities, we combine the latest technologies with rigorous scientific protocols to deliver unparalleled microbiological solutions.
Aurigene services
Tailored microbiological solutions
Aurigene’s services are built to address the multifaceted challenges of pharmaceutical microbiology. Each service is tailored to ensure precision, compliance, and relevance to the evolving needs of the industry:
Minimum inhibitory concentration (MIC):
Determining the lowest concentration of an antimicrobial agent that inhibits visible microbial growth. MIC testing is conducted using both agar and broth dilution methodologies, providing insights into the activity of New Chemical Entities (NCEs).
Minimum bactericidal concentration (MBC):
Identifying the lowest concentration of an antimicrobial agent that achieves 99.9% bacterial killing, ensuring that drugs meet bactericidal efficacy standards.
Method applied
- Broth micro-dilution
- Broth macro-dilution
- Disk diffusion ,and
- Agar dilution
Conducted per CLSI guidelines with IBSC approvals.
Our team specializes in pharmacodynamic studies that delve into the drug-organism interaction:
- Time kill kinetics: Assessing the time course and rate of antimicrobial activity.
- Post-antibiotic effect (PAE): Studying the persistent suppression of bacterial regrowth following brief drug exposure.

Our murine infection models simulate real-world infection scenarios to evaluate the efficacy of anti-infective agents:
- Systemic infection models: Generating proof of concept (POC) and determining ED50 in acute lethal infection scenarios.
- Respiratory tract infection models:Testing NCE efficacy in highly vascularized tissues like the lungs.

- Thigh and urinary tract infection models: Studying drug efficacy in poorly vascularized tissues and clearing UTIs.
- Organ burden models: Quantifying drug efficacy in reducing microbial loads in systemic infections.
Specialties: expertise that sets us apart
Aurigene’s specialties reflect our deep expertise and focus on excellence:
Anti-infective
expertise
Our team has successfully collaborated on numerous antibacterial and antifungal discovery projects with leading pharmaceutical innovators.
Regulatory
proficiency
Our services are backed by extensive experience in regulatory submissions, ensuring smooth product approvals.
Advanced
Pharmacodynamic Studies
From MIC and MBC determinations to biofilm studies and combination therapy evaluations, we provide end-to-end solutions for antimicrobial testing.
Customization
We design assays and models tailored to specific client requirements.
Comprehensive In Vitro and In Vivo assays
Our broad service portfolio addresses the complete spectrum of microbiological needs.
Further scope of the broad field
The landscape of pharmaceutical microbiology is evolving rapidly, mostly driven by emerging technologies, novel therapeutic modalities, and anincreasing focus on sustainability and personalized medicine. For a forward-thinking CDMO like Aurigene, this presents not just challenges but a plethora of opportunities to innovate, diversify, and expand service offerings.
Microbiome-based therapeutics
As the microbiome emerges as a critical player in health and disease, pharmaceutical microbiology can expand its scope toward microbiome-modulating therapeutics. This involves studying the interactions between the human microbiome and drugs, developing assays for probiotics and prebiotics, and even assisting clients in creating "bugs as drugs" for conditions such as inflammatory bowel disease, cancer, and metabolic disorders.
Addressing biofilm challenges
CDMOs can cater efforts to develop specialized services focused on biofilm characterization, prevention strategies, and eradication protocols, as biofilms remain a formidable challenge in drug delivery systems and medical devices. These services can be integrated into device compatibility studies and antimicrobial product testing.
Accelerating microbial testing
Current microbiological testing methods typically require extended timelines. The adoption of Rapid Microbial Detection Systems (RMDs) can significantly reduce testing durations, improving turnaround times for clients. CDMOs can invest in automation, robotics, and AI-powered platforms to facilitate real-time microbial monitoring and predictive contamination analytics, leading to streamlined workflows while ensuring precision and compliance.
Single-cell microbiology
Single-cell analysis is a burgeoning area in microbiology. CDMOs can explore this domain to provide high-resolution phenotypic profiling of microbes, enabling clients to understand microbial behavior at the cellular level. This approach could revolutionize susceptibility testing, uncovering nuanced microbial responses to antimicrobials and environmental changes.
Real-time environmental monitoring
Future services can incorporate real-time environmental monitoring systems that utilize IoT-enabled sensors and machine learning algorithms. These systems can continuously assess air, water, and surface quality in pharmaceutical production facilities, providing predictive alerts for contamination risks.
Biologics and gene therapy testing
With the rise of biologics and cell/gene therapies, there’s a growing need for microbiological testing tailored to these modalities. CDMOs can develop services such as viral safety testing, mycoplasma detection in cell cultures, and contamination testing in gene therapy vectors, ensuring the safety and efficacy of these advanced therapies.
Ai-driven microbial insights
The vast amount of data generated by microbial assays can be analyzed using AI and crucial insights can be obtained. By integrating AI tools, CDMOs can offer enhanced insights into microbial trends, contamination patterns, and even predictive failure analyses. These capabilities could support clients in making data-driven decisions during drug development.
Next-gen anti-infective models
For anti-infective drug discovery, CDMOs can develop next-generation in vivo models using advanced imaging techniques and genetically modified animal models. These can provide deeper insights into infection dynamics and drug efficacy while adhering to ethical standards and reducing animal use.
Combating antimicrobial resistance (AMR)
The global threat of AMR demands innovative solutions. CDMOs can offer specialized services for AMR studies, including resistance profiling, combination therapy evaluations, and AMR biomarker discovery. Partnering with pharmaceutical companies to develop next-gen antimicrobials and stewardship strategies could further establish leadership in this critical area.
Personalized medicine application
With personalized medicine gaining traction, CDMOs can provide services for tailoring anti-infective therapies. This could include genotypic and phenotypic profiling of microbial infections to guide precision antimicrobial therapies, reducing the risk of resistance and improving patient outcomes.
Regulatory advisory services
On the regulatory front, as the related requirements evolve, CDMOs can strengthen their role as partners in compliance. This includes offering regulatory advisory services, preparing submissions for microbial quality control data, and assisting clients in navigating global guidelines, such as EMA, FDA, and PIC/S updates.
Sustainability in microbiology
A growing emphasis on sustainability in the pharmaceutical industry opens new avenues. CDMOs can adopt eco-friendly testing protocols, reduce resource-intensive methods, and even offer green microbiological testing services, such as biodegradable media or energy-efficient testing setups.
Redefining the future of pharmaceutical microbiology
It is needless to mention that the future of pharmaceutical microbiology goes beyond just testing—it’s about embracing a collaborative, innovative, and adaptive mindset. For Aurigene, this isn't just about keeping up—it’s about staying ahead of the curve. By leveraging newer technologies, exploring new therapeutic domains, and committing to sustainability and precision, Aurigene can redefine the scope of CDMO services in pharmaceutical microbiology.
